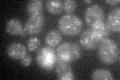
YDR456W
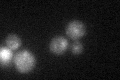
YDR456W

View description
Endosomal Na+/H+ exchanger, required for intracellular sequestration of Na+; required for osmotolerance to acute hypertonic shock
Localization:
Intensity:
Fold change:
Significance:
-
C’ GFP library in SD
punctate30.22 -
N' NOP1pr-GFP in SD

ER74.6498 -
N' TEF2pr-mCherry in SD

ER66.9056 -
N' NATIVEpr-GFP in SD

below threshold24.7214 -
N' TEF2pr-VC and Cyto-VN in SD

below threshold25.9661 -
C’ GFP library in SD+DTT

punctate29.610.97No -
C’ GFP library in SD+H2O2
punctate27.140.89No -
C’ GFP library in Starvation Media

punctate40.881.35Yes -
C’ GFP library on the background of Pup2-DaMP

N/A -
C’ GFP library on the background of CCT mutant

N/A0N/AYes
